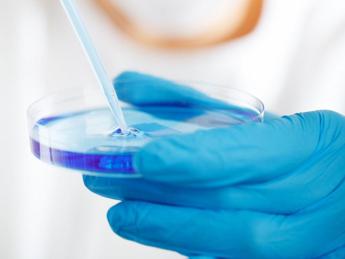
Viareggio. Pro Vita Famiglia: egoista pretendere figlio a 63 anni. Rispettare leggi naturali sulla procreazione

Viareggio. Pro Vita Famiglia: egoista pretendere figlio a 63 anni. Rispettare leggi naturali sulla procreazione
(Adnkronos) – 6 giugno 2024. “La fecondazione artificiale è una procedura già di per sé gravemente immorale per moltissime ragioni, a partire dallo sterminio di embrioni umani necessario per arrivare con successo a una singola fecondazione, ma sfruttarla per partorire un figlio a 63 anni mette veramente in luce l’aberrante mentalità del ‘diritto al figlio’. Quando questo bambino avrà appena 10 anni la madre ne avrà già 73 e sarà nel pieno declino delle forze fisiche di cui avrebbe bisogno per aiutare e seguire il figlio nelle sue attività quotidiane. Inoltre, dato che in Italia l’aspettativa di vita di una donna si aggira intorno agli 84 anni, questa donna ha manipolato la scienza e la stessa vita umana per partorire un figlio che, statisticamente, sarà orfano di madre già intorno ai 20 anni. Questo caso di plateale egoismo richiama alle nostre coscienze l’urgenza di rispettare le leggi di natura che regolano la procreazione, un processo tanto meraviglioso quanto delicato che non riguarda solo le comprensibili aspirazioni degli adulti ma anche la vita degli esseri umani che verranno ad esistere”. Lo afferma in una nota Jacopo Coghe, portavoce di Pro Vita & Famiglia Onlus, in merito al caso della donna lucchese che il 3 giugno ha partorito un figlio a 63 anni all’Ospedale Versilia a Lido di Camaiore, dopo aver praticato per due volte la fecondazione artificiale in Ucraina. Ufficio Stampa Pro Vita e Famiglia Onlus t.: 0694325503 m.: 3929042395 —immediapresswebinfo@adnkronos.com (Web Info)
